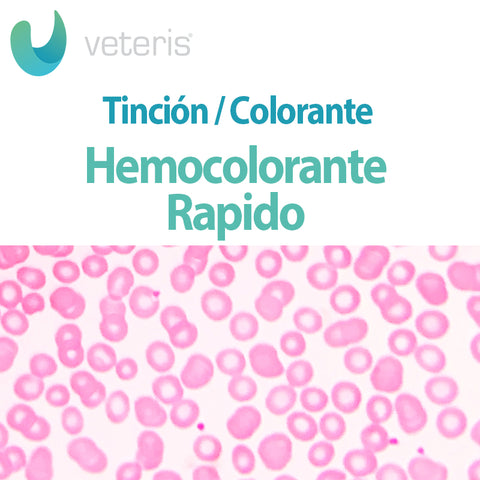

Hemocolorante Rápido
548 | Nacional
Descripción del producto
Hemocolorante Rápido
Equipo de colorantes para tinción policromatica manual, rápida de frotis sanguíneo. Incluye: Eosina Amarillenta en amortiguador de fosfatos, Azur-Azul de metileno en amortiguador de fosfatos y Solución fijadora. (Diff Quick)
Presentación: 100 ml.
Comparte este producto
